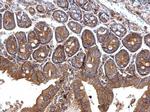
TGFBR1 Antibody in Immunohistochemistry (Paraffin) (IHC (P))

Search
Invitrogen
TGFBR1 Polyclonal Antibody
{{$productOrderCtrl.translations['antibody.pdp.commerceCard.promotion.promotions']}}
{{$productOrderCtrl.translations['antibody.pdp.commerceCard.promotion.viewpromo']}}
{{$productOrderCtrl.translations['antibody.pdp.commerceCard.promotion.promocode']}}: {{promo.promoCode}} {{promo.promoTitle}} {{promo.promoDescription}}. {{$productOrderCtrl.translations['antibody.pdp.commerceCard.promotion.learnmore']}}
产品信息
PA5-27785
宿主/亚型
分类
类型
抗原
偶联物
形式
浓度
规格
保存条件
运输条件
RRID
产品详细信息
PA5-27785 targets TGF beta Receptor I in IF, IHC (P), and WB applications and shows reactivity with Human and Rat samples.
The PA5-27785 immunogen is recombinant protein fragment corresponding to a region within amino acids 1 and 268 of Human TGF beta Receptor I.
靶标信息
TGFBR1 is a transmembrane serine/threonine kinase in the TGFBR1 superfamily, which also includes ACVRs and BMPRs. Upon binding TGF-b, TGFBR2 dimerizes with and activates TGFBR1 via phosphorylation leading to downstream phosphorylation of SMADs by TGFBR1. TGFBR1 forms a heteromeric complex with type II TGF-beta receptors when bound to TGF-beta, transducing the TGF-beta signal from the cell surface to the cytoplasm. The encoded protein is a serine/threonine protein kinase. Mutations in this gene have been associated with Loeys-Dietz aortic aneurysm syndrome (LDAS).
仅用于科研。不用于诊断过程。未经明确授权不得转售。